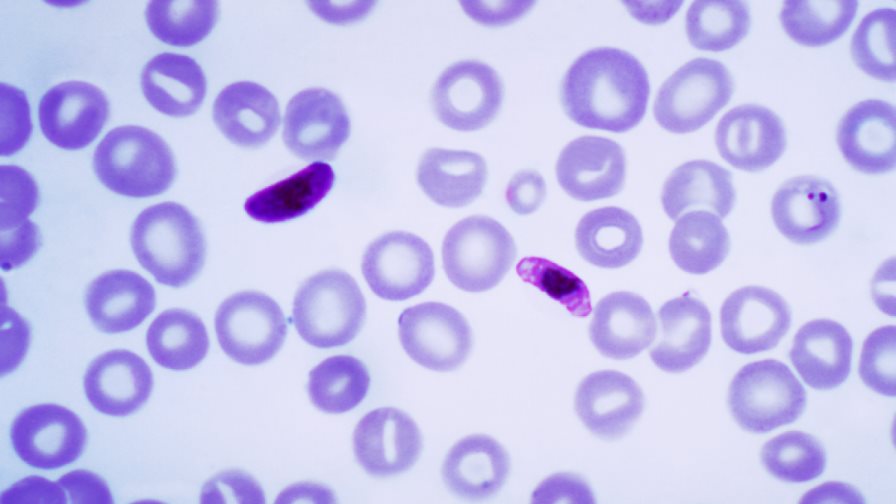
Científicos estudian anticuerpos para crear una vacuna contra la malaria

Científicos estudian anticuerpos para crear una vacuna contra la malaria
El estudio señala que la infección de malaria ocasiona que los antígenos del parásito se manifiesten en la superficie de las células rojas
LONDRES. Encontrar los anticuerpos que sean capaces de combatir la malaria podría ser útil a la hora de diseñar una vacuna contra esta enfermedad, según señala un grupo de expertos en un estudio publicado hoy por la revista Nature.
Este equipo de científicos liderado por Antonio Lanzavec, de la Universitá della Svizzera Italiana, en Suiza, identifica en la citada publicación nuevos objetivos que podrían ser empleados para desarrollar una inmunización contra la malaria basada en anticuerpos.
El estudio señala que la infección de malaria, que es provocada con frecuencia por el parásito “Plasmodium falciparum”, ocasiona que los antígenos del parásito se manifiesten en la superficie de las células rojas.
Por ello, considera que encontrar los anticuerpos capaces de combatir a esos antígenos podría ser útil a la hora de diseñar un nuevo tratamiento, si bien su identificación ha sido escurridiza hasta la fecha para la comunidad científica.
Lanzavecchia y su equipo estudiaron el plasma de dos individuos de Kenia infectados por malaria e identificaron tipos específicos de células blancas, conocidas como clónicas B, que producen anticuerpos que actúan contra las que están infectadas.
Mostraron que insertar fragmentos grandes de ADN dentro de la parte codificada de los anticuerpos de la proteína LAIR1 -que reacciona y se adhiere a antígenos específicos (RIFINs) en células rojas infectadas- hace que esas células sean susceptibles a la fagocitosis, el proceso mediante el cual las células rojas que están infectadas por el parásito se destruyen.
Los expertos apuntaron que continúa estando poco claro si en estudios futuros este mecanismo de inserción del ADN tendrá éxito a la hora de producir anticuerpos que resulten funcionales.
No obstante, los autores del estudio sugieren que las partes que se conserven del antígeno al que se adhieren los anticuerpos podrían ser candidatas adecuadas para el desarrollo de la vacuna de la malaria.
EFE
EFE